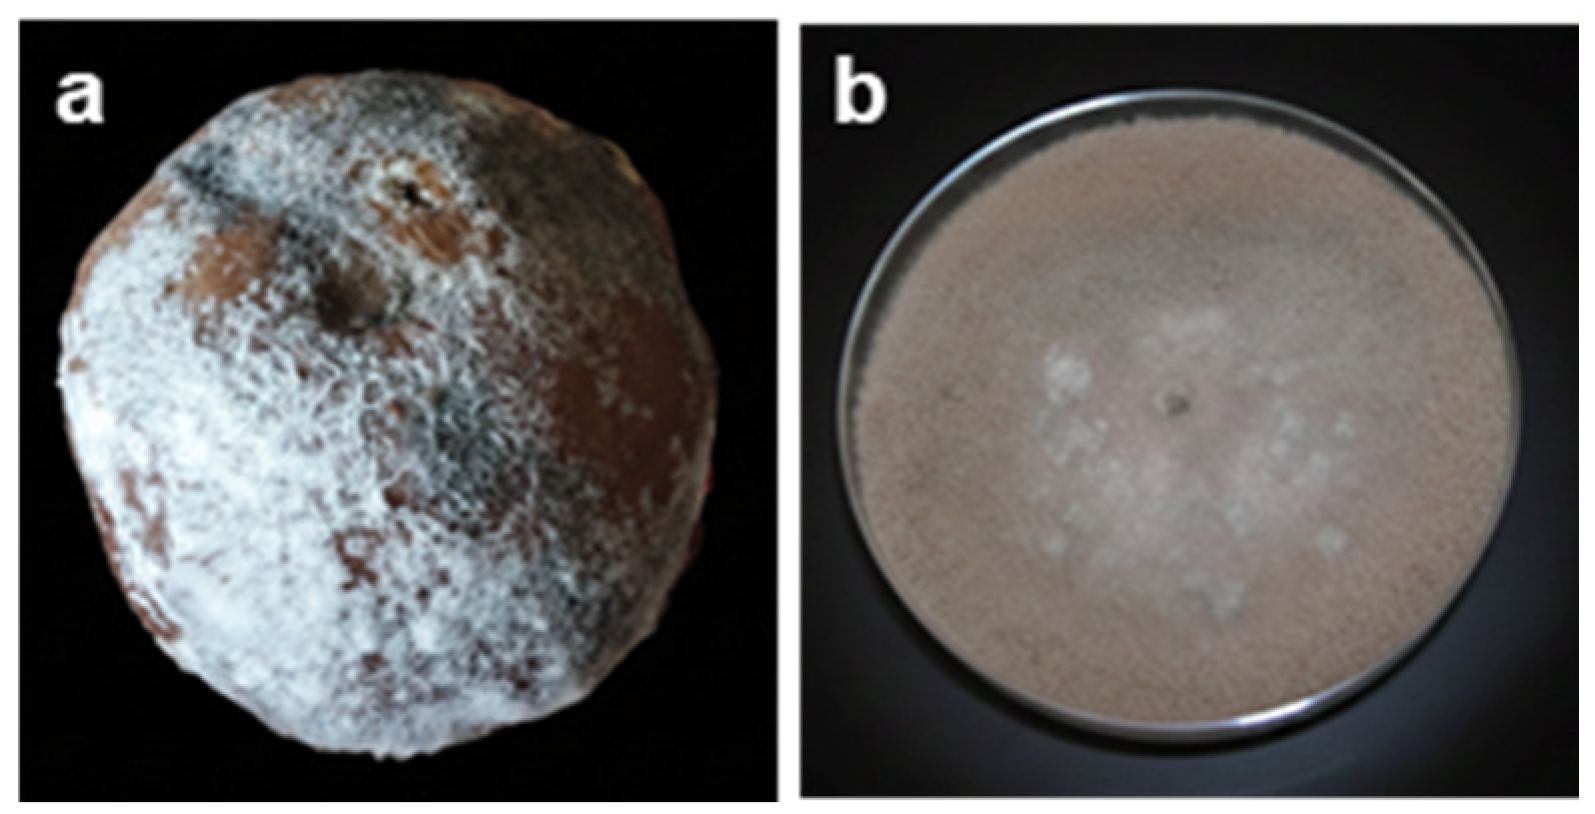
Crops 05 00084 g007 Crops 05 00084 g007

Peach Postharvest Fungal Diseases: Sustainable Management and an Integrative Review of Emerging Strategies
Abstract
1. Introduction
2. Postharvest Rot of Peaches
2.1. Brown Rot
2.2. Blue Rot
2.3. Soft Rot
2.4. Gray Rot
2.5. Acid Rot
2.6. Comparative Overview of Major Postharvest Fungal Pathogens in Peach
3. Methods for Controlling Postharvest Rots of Peach
3.1. Chemical Controls
3.1.1. Fungicides Synthetic/Chemical Fungicides
3.1.2. Plant Defense Activators
- β-aminobutyric Acid
- 2,4-epibrassinolide and Methyl Jasmonate
- Benzothiadiazole
- 6-benzylaminopurine
- Nitric Oxide and Sodium Metasilicate
- Essential oils treatments
3.1.3. Sanitizers
- Neutral electrolyzed water
- Hydrogen peroxide
- Ozone
- Peracetic Acid
- Acetic Acid
- Calcium Chloride and Sodium Hypochlorite
3.2. Physical Controls
3.2.1. Heat Treatments
- Hot water Treatments
- Hot Air Treatments
3.2.2. UV Treatments
3.2.3. Other Physical Techniques
3.3. Biological Controls
Antagonists Treatment
- Bacterial treatment
- Yeast Treatment
3.4. Comparative Evaluation of Postharvest Rot Control Methods
| Control Method | Efficacy | Residue Risk | Resistance Risk | Environmental Impact | Cost | Industrial Applicability | Comments | Refs. |
|---|---|---|---|---|---|---|---|---|
| Chemical Fungicides | High | High | High | Negative | Moderate | High | Fast action, widely used, but declining acceptance | [133,134] |
| Biological Control | Moderate | None | Low | Positive | Moderate–High | Medium | Eco-friendly, needs formulation and storage stability | [135] |
| Physical Treatments | Moderate–High | None | None | Neutral to positive | High | Medium | Effective if optimized, may stress fruit tissues | [136,137] |
| Integrated Methods | High (synergistic) | Low | Low | Positive | Variable | Medium–High | Combines benefits, requires protocol optimization | [138] |
4. Conclusions and Research Gaps
Author Contributions
Funding
Data Availability Statement
Acknowledgments
Conflicts of Interest
References
- Liu, H.; Cao, J.; Jiang, W. Evaluation and Comparison of Vitamin C, Phenolic Compounds, Antioxidant Properties and Metal Chelating Activity of Pulp and Peel from Selected Peach Cultivars. LWT-Food Sci. Technol. 2015, 63, 1042–1048. [Google Scholar] [CrossRef]
- Zhao, X.; Zhang, W.; Yin, X.; Su, M.; Sun, C.; Li, X.; Chen, K. Phenolic Composition and Antioxidant Properties of Different Peach [Prunus Persica (L.) Batsch] Cultivars in China. Int. J. Mol. Sci. 2015, 16, 5762–5778. [Google Scholar] [CrossRef]
- FAOSTAT. Available online: https://www.fao.org/faostat/fr/#rankings/countries_by_commodity (accessed on 14 September 2025).
- Zhang, S.; Zheng, Q.; Xu, B.; Liu, J. Identification of the Fungal Pathogens of Postharvest Disease on Peach Fruits and the Control Mechanisms of Bacillus subtilis JK-14. Toxins 2019, 11, 322. [Google Scholar] [CrossRef]
- Li, Z.; Nie, J.; Yan, Z.; Cheng, Y.; Lan, F.; Huang, Y.; Chen, Q.; Zhao, X.; Li, A. A Monitoring Survey and Dietary Risk Assessment for Pesticide Residues on Peaches in China. Regul. Toxicol. Pharmacol. 2018, 97, 152–162. [Google Scholar] [CrossRef]
- Schebesta, H.; Bernaz, N.; Macchi, C. The European Union Farm to Fork Strategy. Eur. Food Feed Law Rev. 2020, 15, 420–427. [Google Scholar]
- Lesik, K. Monilinia Species Causing Fruit Brown Rot, Blossom and Twig Blight in Apple Orchards in Belarus. Proc. Latv. Acad. Sci. Sect. B Nat. Exact Appl. Sci. 2013, 67, 192–194. [Google Scholar] [CrossRef]
- Monilinia fructigena-Brown Rot of Fruit—Discover Life. Available online: https://www.discoverlife.org/mp/20q?search=Monilinia+fructigena (accessed on 24 September 2025).
- Oliveira Lino, L.; Pacheco, I.; Mercier, V.; Faoro, F.; Bassi, D.; Bornard, I.; Quilot-Turion, B. Brown Rot Strikes Prunus Fruit: An Ancient Fight Almost Always Lost. J. Agric. Food Chem. 2016, 64, 4029–4047. [Google Scholar] [CrossRef] [PubMed]
- De Cal, A.; Gell, I.; Usall, J.; Viñas, I.; Melgarejo, P. First Report of Brown Rot Caused by Monilinia fructicola in Peach Orchards in Ebro Valley, Spain. Plant Dis. 2009, 93, 763. [Google Scholar] [CrossRef]
- Obi, V.I.; Barriuso, J.J.; Gogorcena, Y. Peach Brown Rot: Still in Search of an Ideal Management Option. Agriculture 2018, 8, 125. [Google Scholar] [CrossRef]
- Villarino, M.; Melgarejo, P.; Usall, J.; Segarra, J.; De Cal, A. Primary Inoculum Sources of Monilinia Spp. in Spanish Peach Orchards and Their Relative Importance in Brown Rot. Plant Dis. 2010, 94, 1048–1054. [Google Scholar] [CrossRef] [PubMed]
- Casals, C.; Viñas, I.; Torres, R.; Griera, C.; Usall, J. Effect of Temperature and Water Activity on in Vitro Germination of Monilinia spp. J. Appl. Microbiol. 2010, 108, 47–54. [Google Scholar] [CrossRef]
- Bernat, M.; Segarra, J.; Xu, X.-M.; Casals, C.; Usall, J. Influence of Temperature on Decay, Mycelium Development and Sporodochia Production Caused by Monilinia fructicola and M. laxa on Stone Fruits. Food Microbiol. 2017, 64, 112–118. [Google Scholar] [CrossRef]
- Bellamy, S.; Shaw, M.; Xu, X. Using Microbes to Suppress Overwintering Inoculum of Monilinia Laxa on Mummified Fruits and to Protect Cherry Blossoms and Fruit from Infection. Front. Hortic. 2024, 3, 1504505. [Google Scholar] [CrossRef]
- Luciano-Rosario, D.; Keller, N.P.; Jurick, W.M. Penicillium expansum: Biology, Omics, and Management Tools for a Global Postharvest Pathogen Causing Blue Mould of Pome Fruit. Mol. Plant Pathol. 2020, 21, 1391–1404. [Google Scholar] [CrossRef]
- Prusky, D.; Lichter, A. Activation of Quiescent Infections by Postharvest Pathogens during Transition from the Biotrophic to the Necrotrophic Stage. FEMS Microbiol. Lett. 2007, 268, 1–8. [Google Scholar] [CrossRef] [PubMed]
- Wang, C.W.; Ai, J.; Lv, H.Y.; Qin, H.Y.; Yang, Y.M.; Liu, Y.X.; Fan, S.T. First Report of Penicillium expansum Causing Postharvest Decay on Stored Kiwifruit (Actinidia arguta) in China. Plant Dis. 2015, 99, 1037. [Google Scholar] [CrossRef]
- Errampalli, D. Penicillium expansum (Blue Mold). In Postharvest Decay; Bautista-Baños, S., Ed.; Academic Press: San Diego, CA, USA, 2014; pp. 189–231. ISBN 978-0-12-411552-1. [Google Scholar]
- Razzaq, A. Penicillium|Life Cycle|Importance|Occurrence|. Study Solut. 2016. Available online: https://istudy.pk/penicillium/ (accessed on 5 November 2025).
- Sattar, A.; Riaz, A.; Mehmood, N.; Altaf, R.; Afzal, A.; Jabeen, Z. Effect of Incubation Temperature on Lesion Diameter of Penicillium expansum on Apple Fruit Varieties. Int. J. Biosci. 2018, 12, 1–5. [Google Scholar]
- Lahlali, R.; Friel, D.; Serrhini, M.N.; Jijakli, M. Effect of Incubation Temperature and Relative Humidity on Lesion Diameter of Botrytis cinerea Pers. and Penicillium expansum Link. on Apple Fruits. Commun. Agric. Appl. Biol. Sci. 2006, 71, 1161. [Google Scholar]
- Tannous, J.; Atoui, A.; El Khoury, A.; Francis, Z.; Oswald, I.P.; Puel, O.; Lteif, R. A Study on the Physicochemical Parameters for Penicillium expansum Growth and Patulin Production: Effect of Temperature, pH, and Water Activity. Food Sci. Nutr. 2016, 4, 611–622. [Google Scholar] [CrossRef]
- Tannous, J.; Keller, N.P.; Atoui, A.; El Khoury, A.; Lteif, R.; Oswald, I.P.; Puel, O. Secondary Metabolism in Penicillium expansum: Emphasis on Recent Advances in Patulin Research. Crit. Rev. Food Sci. Nutr. 2018, 58, 2082–2098. [Google Scholar] [CrossRef]
- Saleh, I.; Goktepe, I. The Characteristics, Occurrence, and Toxicological Effects of Patulin. Food Chem. Toxicol. 2019, 129, 301–311. [Google Scholar] [CrossRef]
- Sun, M.-H.; Li, X.-H.; Xu, Y.; Xu, Y.; Pan, Z.-N.; Sun, S.-C. Citrinin Exposure Disrupts Organelle Distribution and Functions in Mouse Oocytes. Environ. Res. 2020, 185, 109476. [Google Scholar] [CrossRef] [PubMed]
- Zhou, D.; Wang, Z.; Li, M.; Xing, M.; Xian, T.; Tu, K. Carvacrol and Eugenol Effectively Inhibit Rhizopus stolonifer and Control Postharvest Soft Rot Decay in Peaches. J. Appl. Microbiol. 2018, 124, 166–178. [Google Scholar] [CrossRef] [PubMed]
- Schipper, M.A.A. A Revision of the Genus Rhizopus. I. The Rhizopus stolonifer-Group and Rhizopus Oryzae. Stud. Mycol. 1984, 25, 19. [Google Scholar]
- Swingle, D.B. Formation of the Spores in the Sporangia of Rhizopus Nigricans and of Phycomyces Nitens; US Government Printing Office: Washington, DC, USA, 1903.
- Holmes, G.J.; Stange, R.R. Influence of Wound Type and Storage Duration on Susceptibility of Sweetpotatoes to Rhizopus Soft Rot. Plant Dis. 2002, 86, 345–348. [Google Scholar] [CrossRef]
- Amiri, A.; Chai, W.; Schnabel, G. Effect of Nutrient Status, pH, Temperature and Water Potential on Germination and Growth of Rhizopus stolonifer and Gilbertella Persicaria. J. Plant Pathol. 2011, 93, 603–612. [Google Scholar]
- Mena-Nevarez, G.; Valencia-Del Toro, G.; Piña-Guzmán, A.B.; Villanueva-Arce, R.; Durán-Páramo, E.; Robles-Martínez, F. Degradation Capacity of Fungi (Colletotrichum sp., Penicillium sp. and Rhizopus sp.) on Mangoes and Oranges. Afr. J. Agric. Res. 2012, 7, 4564–4574. [Google Scholar] [CrossRef]
- Al-Hindi, R.R.; Al-Najada, A.R.; Mohamed, S.A. Isolation and Identification of Some Fruit Spoilage Fungi: Screening of Plant Cell Wall Degrading Enzymes. Afr. J. Microbiol. Res. 2011, 5, 443–448. [Google Scholar]
- Vazhacharikal, P.J.; Mathew, J.J.; Sajeshkumar, N.K.; Prathap, P. Effect of Concentration and pH on the Preservative Action of Calcium Propionate against Black Bread Mold (Rhizopus stolonifer) in Kerala. CIBTech J. Biotechnol. 2015, 4, 1–12. [Google Scholar]
- Hua, L.; Yong, C.; Zhanquan, Z.; Boqiang, L.; Guozheng, Q.; Shiping, T. Pathogenic Mechanisms and Control Strategies of Botrytis cinerea Causing Post-Harvest Decay in Fruits and Vegetables. Food Qual. Saf. 2018, 2, 111–119. [Google Scholar] [CrossRef]
- Elad, Y.; Pertot, I.; Cotes Prado, A.M.; Stewart, A. Plant Hosts of Botrytis Spp. In Botrytis—The Fungus, the Pathogen and Its Management in Agricultural Systems; Fillinger, S., Elad, Y., Eds.; Springer International Publishing: Cham, Switzerland, 2016; pp. 413–486. ISBN 978-3-319-23370-3. [Google Scholar]
- Morales-Valle, H.; Silva, L.C.; Paterson, R.R.M.; Venâncio, A.; Lima, N. Effects of the Origins of Botrytis cinerea on Earthy Aromas from Grape Broth Media Further Inoculated with Penicillium expansum. Food Microbiol. 2011, 28, 1048–1053. [Google Scholar] [CrossRef]
- Williamson, B.; Tudzynski, B.; Tudzynski, P.; Van Kan, J.A.L. Botrytis cinerea: The Cause of Grey Mould Disease. Mol. Plant Pathol. 2007, 8, 561–580. [Google Scholar] [CrossRef]
- Yoder, O.C.; Whalen, M.L. Factors Affecting Postharvest Infection of Stored Cabbage Tissue by Botrytis cinerea. Can. J. Bot. 1975, 53, 691–699. [Google Scholar] [CrossRef]
- Barnett, H.L.; Hunter, B.B. Illustrated Genera of Imperfect Fungi; APS Press: St. Paul, MN, USA, 1998. [Google Scholar]
- Jarvis, W.R. Botryotinia and Botrytis Species: Taxonomy, Physiology and Pathogenicity—A Guide to the Literature; Agriculture and Agri Food Canada: Ottawa, ON, Canada, 1977. [Google Scholar]
- Fukumori, Y.; Nakajima, M.; Akutsu, K. Microconidia Act the Role as Spermatia in the Sexual Reproduction of Botrytis cinerea. J. Gen. Plant Pathol. 2004, 70, 256–260. [Google Scholar] [CrossRef]
- Ciliberti, N.; Fermaud, M.; Roudet, J.; Languasco, L.; Rossi, V. Environmental Effects on the Production of Botrytis cinerea Conidia on Different Media, Grape Bunch Trash, and Mature Berries: Sporulation Patterns in Botrytis cinerea. Aust. J. Grape Wine Res. 2016, 22, 262–270. [Google Scholar] [CrossRef]
- Tan, K.K.; Epton, H.A.S. Effect of Light on the Growth and Sporulation of Botrytis cinerea. Trans. Br. Mycol. Soc. 1973, 61, 145–157. [Google Scholar] [CrossRef]
- van Kan, J.A. Infection Strategies of Botrytis cinerea. In Proceedings of the VIII International Symposium on Postharvest Physiology of Ornamental Plants, Doorwerth, The Netherlands, 10–14 August 2003; Volume 669, pp. 77–90. [Google Scholar]
- Wojtaszek, P. Oxidative Burst: An Early Plant Response to Pathogen Infection. Biochem. J. 1997, 322, 681–692. [Google Scholar] [CrossRef] [PubMed]
- Amselem, J.; Cuomo, C.A.; van Kan, J.A.; Viaud, M.; Benito, E.P.; Couloux, A.; Coutinho, P.M.; de Vries, R.P.; Dyer, P.S.; Fillinger, S. Genomic Analysis of the Necrotrophic Fungal Pathogens Sclerotinia Sclerotiorum and Botrytis cinerea. PLoS Genet. 2011, 7, e1002230. [Google Scholar] [CrossRef]
- Halfeld-Vieira, B.A.; Terao, D.; Nechet, K.L. First Report of Geotrichum Candidum Causing Sour-Rot of Melon in Brazil. Plant Dis. 2020, 104, 1537. [Google Scholar] [CrossRef]
- Cheng, H.; Tang, W.; Wang, H.; Liu, Q.; Li, H.; Liu, Y. First Report of Geotrichum candidum Causing Postharvest Sour Rot on Kiwifruits in China. Plant Dis. 2021, 105, 1566. [Google Scholar] [CrossRef]
- Chantarasiri, A.; Boontanom, P.; Siriprom, W.; Kongsriprapan, S. First Report of Geotrichum candidum Causing Sour Rot of Longkong Fruits (Lansium domesticum) in Southern Thailand. New Dis. Rep. 2021, 43, e12016. [Google Scholar] [CrossRef]
- Alonzo, G.; Lopes, U.P.; Wang, N.-Y.; Peres, N.A. First Report of Sour Rot of Strawberry Caused by Geotrichum Candidum in the United States. Plant Dis. 2021, 105, 225. [Google Scholar] [CrossRef]
- Thomidis, T.; Prodromou, I.; Farmakis, A.; Zambounis, A. Effect of Temperature on the Growth of Geotrichum candidum and Chemical Control of Sour Rot on Tomatoes. Trop. Plant Pathol. 2021, 46, 545–552. [Google Scholar] [CrossRef]
- Alam, M.W.; Rehman, A.; Malik, A.U.; Iqbal, Z.; Amin, M.; Ali, S.; Hameed, A.; Sarfraz, S. First Report of Geotrichum Candidum Causing Postharvest Sour Rot of Peach in Punjab, Pakistan. Plant Dis. 2017, 101, 1543. [Google Scholar] [CrossRef]
- Li, Y.; Hind, C.; Furner-Pardoe, J.; Sutton, J.M.; Rahman, K.M. Understanding the Mechanisms of Resistance to Azole Antifungals in Candida Species. JAC-Antimicrob. Resist. 2025, 7, dlaf106. [Google Scholar] [CrossRef]
- Kaur, J.; Nobile, C.J. Antifungal Drug-Resistance Mechanisms in Candida Biofilms. Curr. Opin. Microbiol. 2023, 71, 102237. [Google Scholar] [CrossRef] [PubMed]
- Jay, A.; Jordan, D.F.; Gerstein, A.; Landry, C.R. The Role of Gene Copy Number Variation in Antimicrobial Resistance in Human Fungal Pathogens. npj Antimicrob. Resist. 2025, 3, 1. [Google Scholar] [CrossRef]
- Yoshimi, A.; Kojima, K.; Takano, Y.; Tanaka, C. Group III Histidine Kinase Is a Positive Regulator of Hog1-Type Mitogen-Activated Protein Kinase in Filamentous Fungi. Eukaryot Cell 2005, 4, 1820–1828. [Google Scholar] [CrossRef] [PubMed]
- Jacob, J.J.; Bevan, J.S. Should All Patients with Acromegaly Receive Somatostatin Analogue Therapy before Surgery and, If so, for How Long? Clin. Endocrinol. 2014, 81, 812–817. [Google Scholar] [CrossRef]
- Billard, A. Fenhexamid: Mode d’Action et Résistance Chez le Complex d’Espèces Botrytis spp., Responsable de La Pourriture Grise de La Vigne; Université Paris Sud-Paris 11: Paris, France, 2011. [Google Scholar]
- Malandrakis, A.A.; Lafka, E.; Flouri, F. Impact of Fludioxonil Resistance on Fitness and Cross-Resistance Profiles of Altrenaria Solani Laboratory Mutants. Eur. J. Plant Pathol. 2021, 161, 665–676. [Google Scholar] [CrossRef]
- Daniels, A.; Lucas, J.A. Mode of Action of the Anilino-pyrimidine Fungicide Pyrimethanil. 1. In-vivo Activity against Botrytis Fabae on Broad Bean (Vicia faba) Leaves. Pestic. Sci. 1995, 45, 33–41. [Google Scholar] [CrossRef]
- Fritz, R.; Lanen, C.; Colas, V.; Leroux, P. Inhibition of Methionine Biosynthesis in Botrytis cinerea by the Anilinopyrimidine Fungicide Pyrimethanil. Pestic. Sci. 1997, 49, 40–46. [Google Scholar] [CrossRef]
- Jacob, S.; Brandhorst, T.T. The Mechanism of Phenylpyrrole Fungicides Cannot Be Explained by a Stearic Effect upon Triososephosphate Isomerase Alone. J. Med. Microbiol. 2020, 96, 523–538. [Google Scholar]
- Li, C.; Wang, K.; Huang, Y.; Lei, C.; Cao, S.; Qiu, L.; Xu, F.; Jiang, Y.; Zou, Y.; Zheng, Y. Activation of the BABA-induced Priming Defence through Redox Homeostasis and the Modules of TGA1 and MAPKK5 in Postharvest Peach Fruit. Mol. Plant Pathol. 2021, 22, 1624–1640. [Google Scholar] [CrossRef]
- Li, C.H.; Du, M.Y.; Wang, K.T. 2, 4-Epibrassionolide Activates Priming Resistance against Rhizopus stolonifer Infection in Peach Fruit. Acta Aliment. 2020, 49, 135–143. [Google Scholar] [CrossRef]
- Ji, N.; Wang, J.; Zuo, X.; Li, Y.; Li, M.; Wang, K.; Jin, P.; Zheng, Y. PpWRKY45 Is Involved in Methyl Jasmonate Primed Disease Resistance by Enhancing the Expression of Jasmonate Acid Biosynthetic and Pathogenesis-Related Genes of Peach Fruit. Postharvest Biol. Technol. 2021, 172, 111390. [Google Scholar] [CrossRef]
- Liu, H.X.; Wang, B.G.; Bi, Y.; Luo, Y.B.; Jiang, W.B. Improving Disease Resistance in Peach Fruit during Storage Using Benzo-(1,2,3)-Thiodiazole-7-Carbothioic Acid S-Methyl Ester (BTH). J. Hortic. Sci. Biotechnol. 2005, 80, 736–740. [Google Scholar] [CrossRef]
- Zhang, Y.; Zeng, L.; Yang, J.; Zheng, X.; Yu, T. 6-Benzylaminopurine Inhibits Growth of Monilinia fructicola and Induces Defense-Related Mechanism in Peach Fruit. Food Chem. 2015, 187, 210–217. [Google Scholar] [CrossRef] [PubMed]
- Shi, J.Y.; Liu, N.; Gu, R.X.; Zhu, L.Q.; Zhang, C.; Wang, Q.G.; Lei, Z.H.; Liu, Y.Y.; Ren, J.Y. Signals Induced by Exogenous Nitric Oxide and Their Role in Controlling Brown Rot Disease Caused by Monilinia fructicola in Postharvest Peach Fruit. J. Gen. Plant Pathol. 2015, 81, 68–76. [Google Scholar] [CrossRef]
- Pavanello, E.P.; Brackmann, A.; da Costa, I.F.D.; Both, V.; Ludwig, V. Use of Sodium Metasilicate for Management of Peach Brown Rot. Pesqui. Agropecuária Trop. 2016, 46, 245–253. [Google Scholar] [CrossRef]
- Elshafie, H.S.; Mancini, E.; Camele, I.; De Martino, L.; De Feo, V. In Vivo Antifungal Activity of Two Essential Oils from Mediterranean Plants against Postharvest Brown Rot Disease of Peach Fruit. Ind. Crops Prod. 2015, 66, 11–15. [Google Scholar] [CrossRef]
- Tsao, R.; Zhou, T. Antifungal Activity of Monoterpenoids against Postharvest Pathogens Botrytis cinerea and Monilinia fructicola. J. Essent. Oil Res. 2000, 12, 113–121. [Google Scholar] [CrossRef]
- Alamri, S.A.M.; Hashem, M.; Alqahtani, M.S.A.; Alshehri, A.M.A.; Mohamed, Z.A.; Ziedan, E.S.H. Formulation of Mint and Thyme Essential Oils with Arabic Gum and Tween to Enhance Their Efficiency in the Control of Postharvest Rots of Peach Fruit. Can. J. Plant Pathol. 2020, 42, 330–343. [Google Scholar] [CrossRef]
- Cindi, M.D.; Soundy, P.; Romanazzi, G.; Sivakumar, D. Different Defense Responses and Brown Rot Control in Two Prunus Persica Cultivars to Essential Oil Vapours after Storage. Postharvest Biol. Technol. 2016, 119, 9–17. [Google Scholar] [CrossRef]
- Xu, Y.; Wei, J.; Wei, Y.; Han, P.; Dai, K.; Zou, X.; Jiang, S.; Xu, F.; Wang, H.; Sun, J. Tea Tree Oil Controls Brown Rot in Peaches by Damaging the Cell Membrane of Monilinia fructicola. Postharvest Biol. Technol. 2021, 175, 111474. [Google Scholar] [CrossRef]
- Li, Y.; Shao, X.; Xu, J.; Wei, Y.; Xu, F.; Wang, H. Tea Tree Oil Exhibits Antifungal Activity against Botrytis cinerea by Affecting Mitochondria. Food Chem. 2017, 234, 62–67. [Google Scholar] [CrossRef]
- Jiang, S.; Zhao, T.; Wei, Y.; Cao, Z.; Xu, Y.; Wei, J.; Xu, F.; Wang, H.; Shao, X. Preparation and Characterization of Tea Tree Oil/Hydroxypropyl-β-Cyclodextrin Inclusion Complex and Its Application to Control Brown Rot in Peach Fruit. Food Hydrocoll. 2021, 121, 107037. [Google Scholar] [CrossRef]
- Adebayo, O.; Bélanger, A.; Khanizadeh, S. Variable Inhibitory Activities of Essential Oils of Three Monarda Species on the Growth of Botrytis cinerea. Can. J. Plant Sci. 2013, 93, 987–995. [Google Scholar] [CrossRef]
- Camele, I.; Altieri, L.; De Martino, L.; De Feo, V.; Mancini, E.; Rana, G.L. In Vitro Control of Post-Harvest Fruit Rot Fungi by Some Plant Essential Oil Components. Int. J. Mol. Sci. 2012, 13, 2290–2300. [Google Scholar] [CrossRef] [PubMed]
- Xiong, X.; Zhang, L.; Li, X.; Zeng, Q.; Deng, R.; Ren, X.; Kong, Q. Antifungal Mechanisms of Lavender Essential Oil in the Inhibition of Rot Disease Caused by Monilinia fructicola in Postharvest Flat Peaches. Can. J. Microbiol. 2021, 67, 724–736. [Google Scholar] [CrossRef] [PubMed]
- Yan, J.; Wu, H.; Shi, F.; Wang, H.; Chen, K.; Feng, J.; Jia, W. Antifungal Activity Screening for Mint and Thyme Essential Oils against Rhizopus stolonifer and Their Application in Postharvest Preservation of Strawberry and Peach Fruits. J. Appl. Microbiol. 2021, 130, 1993–2007. [Google Scholar] [CrossRef]
- Vásquez-López, A.; Gómez-Jaimes, R.; Villarreal-Barajas, T. Effectiveness of Neutral Electrolyzed Water and Copper Oxychloride on Fungi Spores Isolated from Tropical Fruits. Heliyon 2021, 7, e07935. [Google Scholar] [CrossRef] [PubMed]
- Guentzel, J.L.; Lam, K.L.; Callan, M.A.; Emmons, S.A.; Dunham, V.L. Postharvest Management of Gray Mold and Brown Rot on Surfaces of Peaches and Grapes Using Electrolyzed Oxidizing Water. Int. J. Food Microbiol. 2010, 143, 54–60. [Google Scholar] [CrossRef] [PubMed]
- Yang, M.; Zhang, Y.; Tan, X.; Li, L.; OuYang, Q.; Tao, N. Sodium Cuminate Inhibits the Mycelial Growth of Penicillium Digitatum by Inducing Oxidative Stress and Damaging the Cell Membrane. J. Fungi 2025, 11, 612. [Google Scholar] [CrossRef]
- Rij, R.E.; Forney, C.F. Phytotoxocity of Vapour Phase Hydrogen Peroxide to Thompson Seedless Grapes and Botrytis cinerea Spores. Crop Prot. 1995, 14, 131–135. [Google Scholar] [CrossRef]
- Drogoudi, P.; Pantelidis, G.; Thomidis, T. Impact of Ozonated Water on Brown Rot Development and Storage Potential of Nectarine and Plum. Ozone Sci. Eng. 2023, 45, 410–418. [Google Scholar] [CrossRef]
- Palou, L.; Crisosto, C.H.; Smilanick, J.L.; Adaskaveg, J.E.; Zoffoli, J.P. Effects of Continuous 0.3 Ppm Ozone Exposure on Decay Development and Physiological Responses of Peaches and Table Grapes in Cold Storage. Postharvest Biol. Technol. 2002, 24, 39–48. [Google Scholar] [CrossRef]
- Campayo, A.; De La Hoz, K.S.; García-Martínez, M.M.; Sánchez-Martínez, J.F.; Salinas, M.R.; Alonso, G.L. Spraying Ozonated Water on Bobal Grapevines: Effect on Grape Quality. Food Res. Int. 2019, 125, 108540. [Google Scholar] [CrossRef]
- Sisquella, M.; Casals, C.; Viñas, I.; Teixidó, N.; Usall, J. Combination of Peracetic Acid and Hot Water Treatment to Control Postharvest Brown Rot on Peaches and Nectarines. Postharvest Biol. Technol. 2013, 83, 1–8. [Google Scholar] [CrossRef]
- Lagopodi, A.L.; Cetiz, K.; Koukounaras, A.; Sfakiotakis, E.M. Acetic Acid, Ethanol and Steam Effects on the Growth of Botrytis cinerea in Vitro and Combination of Steam and Modified Atmosphere Packaging to Control Decay in Kiwifruit. J. Phytopathol. 2009, 157, 79–84. [Google Scholar] [CrossRef]
- Sholberg, P.L. Fumigation of Fruit with Short-Chain Organic Acids to Reduce the Potential of Postharvest Decay. Plant Dis. 1998, 82, 689–693. [Google Scholar] [CrossRef]
- Sholberg, P.L.; Gaunce, A.P. Fumigation of Stonefruit with Acetic Acid to Control Postharvest Decay. Crop Prot. 1996, 15, 681–686. [Google Scholar] [CrossRef]
- Ochoa-Velasco, C.E.; Guerrero-Beltrán, J.Á. Postharvest Quality of Peeled Prickly Pear Fruit Treated with Acetic Acid and Chitosan. Postharvest Biol. Technol. 2014, 92, 139–145. [Google Scholar] [CrossRef]
- Shalan, A.M. Post-Harvest Applications by Calcium Chloride and Ascorbic Acid Enhanced Storage Ability of Peach Fruits Cv. Floridaprince. J. Plant Prod. 2020, 11, 179–188. [Google Scholar] [CrossRef]
- Sohail, M.; Ayub, M.; Khalil, S.A.; Zeb, A.; Ullah, F.; Afridi, S.R.; Ullah, R. Effect of Calcium Chloride Treatment on Post Harvest Quality of Peach Fruit during Cold Storage. Int. Food Res. J. 2015, 22, 2225. [Google Scholar]
- Benitez1i, M.M.; Saludes, B.; Rivera, F.R.; Adonis, M.; Sudaria, E.H.; Sudaria, E.; Salabao, A. 1Post-Harvest Characteristics of Tomatoes (Solanum lycopersicum L.) as Affected by Treatment with Hot Water and Sodium Hypochlorite under Three Simple Evaporative Coolers. Asian J. Resour. Manag. Gov. 2021, 1, 24. [Google Scholar]
- Okull, D.O.; Demirci, A.; Rosenberger, D.; LaBorde, L.F. Susceptibility of Penicillium expansum Spores to Sodium Hypochlorite, Electrolyzed Oxidizing Water, and Chlorine Dioxide Solutions Modified with Nonionic Surfactants. J. Food Prot. 2006, 69, 1944–1948. [Google Scholar] [CrossRef]
- Jemric, T.; Ivic, D.; Fruk, G.; Matijas, H.S.; Cvjetkovic, B.; Bupic, M.; Pavkovic, B. Reduction of Postharvest Decay of Peach and Nectarine Caused by Monilinia laxa Using Hot Water Dipping. Food Bioprocess Technol. 2011, 4, 149–154. [Google Scholar] [CrossRef]
- Margosan, D.A.; Smilanick, J.L.; Simmons, G.F.; Henson, D.J. Combination of Hot Water and Ethanol to Control Postharvest Decay of Peaches and Nectarines. Plant Dis. 1997, 81, 1405–1409. [Google Scholar] [CrossRef] [PubMed]
- Wang, L.; Jin, P.; Wang, J.; Gong, H.; Zhang, S.; Zheng, Y. Hot Air Treatment Induces Resistance against Blue Mold Decay Caused by Penicillium expansum in Sweet Cherry (Prunus cerasus L.) Fruit. Sci. Hortic. 2015, 189, 74–80. [Google Scholar] [CrossRef]
- Chen, M.; Jiang, Q.; Yin, X.-R.; Lin, Q.; Chen, J.-Y.; Allan, A.C.; Xu, C.-J.; Chen, K.-S. Effect of Hot Air Treatment on Organic Acid-and Sugar-Metabolism in Ponkan (Citrus reticulata) Fruit. Sci. Hortic. 2012, 147, 118–125. [Google Scholar] [CrossRef]
- Huan, C.; Han, S.; Jiang, L.; An, X.; Yu, M.; Xu, Y.; Ma, R.; Yu, Z. Postharvest Hot Air and Hot Water Treatments Affect the Antioxidant System in Peach Fruit during Refrigerated Storage. Postharvest Biol. Technol. 2017, 126, 1–14. [Google Scholar] [CrossRef]
- Di Francesco, A.; Ippolito, A.; Romanazzi, G. Heat Treatments for the Control of Postharvest Decay of Fresh Fruit: Case Studies of Peach Brown Rot, Kiwifruit Gray Mold and Citrus Green and Blue Molds. Postharvest Biol. Technol. 2026, 231, 113868. [Google Scholar] [CrossRef]
- Abdipour, M.; Hosseinifarahi, M.; Naseri, N. Combination Method of UV-B and UV-C Prevents Post-Harvest Decay and Improves Organoleptic Quality of Peach Fruit. Sci. Hortic. 2019, 256, 108564. [Google Scholar] [CrossRef]
- Bassetto, E.; Amorim, L.; Benato, E.A.; Gonçalves, F.P.; Lourenço, S.A. Effect of UV-C Irradiation on Postharvest Control of Brown Rot (Monilinia fructicola) and Soft Rot (Rhizopus stolonifer) of Peaches. Fitopatol. Bras. 2007, 32, 393–399. [Google Scholar] [CrossRef]
- Syamaladevi, R.M.; Lupien, S.L.; Bhunia, K.; Sablani, S.S.; Dugan, F.; Rasco, B.; Killinger, K.; Dhingra, A.; Ross, C. UV-C Light Inactivation Kinetics of Penicillium expansum on Pear Surfaces: Influence on Physicochemical and Sensory Quality during Storage. Postharvest Biol. Technol. 2014, 87, 27–32. [Google Scholar] [CrossRef]
- Zhang, W.; Jiang, H.; Cao, J.; Jiang, W. UV-C Treatment Controls Brown Rot in Postharvest Nectarine by Regulating ROS Metabolism and Anthocyanin Synthesis. Postharvest Biol. Technol. 2021, 180, 111613. [Google Scholar] [CrossRef]
- Wu, Q.; Shen, C.; Li, J.; Wu, D.; Chen, K. Application of Indirect Plasma-Processed Air on Microbial Inactivation and Quality of Yellow Peaches during Storage. Innov. Food Sci. Emerg. Technol. 2022, 79, 103044. [Google Scholar] [CrossRef]
- Cheng, J.-H.; He, L.; Sun, D.-W.; Pan, Y.; Ma, J. Inhibition of Cell Wall Pectin Metabolism by Plasma Activated Water (PAW) to Maintain Firmness and Quality of Postharvest Blueberry. Plant Physiol. Biochem. 2023, 201, 107803. [Google Scholar] [CrossRef]
- Liu, Y.; Zhang, L.; Hu, T.; Liu, Q.; Zhou, S.; Zhao, Y.; Jatt, A.-N.; Zhang, C.; Gong, H. A New Strategy for Enhancing Postharvest Quality of Sweet Cherry: High-Voltage Electrostatic Field Improves the Physicochemical Properties and Fungal Community. Foods 2024, 13, 3670. [Google Scholar] [CrossRef] [PubMed]
- Pratap-Singh, A.; Shojaei, M.; Singh, A.; Ye, Y.; Mandal, R.; Yan, Y.; Pico, J.; Gerbrandt, E.M.; Castellarin, S.D. Effects of Pulsed Light on the Postharvest Quality and Shelf-Life of Highbush Blueberries (Cv. Draper). Appl. Food Res. 2023, 3, 100273. [Google Scholar] [CrossRef]
- Wang, X.; Zhu, J.; Wei, H.; Ding, Z.; Li, X.; Liu, Z.; Wang, H.; Wang, Y. Biological Control Efficacy of Bacillus Licheniformis HG03 against Soft Rot Disease of Postharvest Peach. Food Control. 2023, 145, 109402. [Google Scholar] [CrossRef]
- Arrebola, E.; Sivakumar, D.; Bacigalupo, R.; Korsten, L. Combined Application of Antagonist Bacillus Amyloliquefaciens and Essential Oils for the Control of Peach Postharvest Diseases. Crop Prot. 2010, 29, 369–377. [Google Scholar] [CrossRef]
- Liu, C.; Yin, X.; Wang, Q.; Peng, Y.; Ma, Y.; Liu, P.; Shi, J. Antagonistic Activities of Volatiles Produced by Two Bacillus Strains against Monilinia fructicola in Peach Fruit. J. Sci. Food Agric. 2018, 98, 5756–5763. [Google Scholar] [CrossRef]
- Zhang, H.; Qiu, Y.; Li, M.; Song, F.; Jiang, M. Functions of Pipecolic Acid on Induced Resistance against Botrytis cinerea and Pseudomonas syringae Pv. Tomato DC3000 in Tomato Plants. J. Phytopathol. 2020, 168, 591–600. [Google Scholar] [CrossRef]
- Lugtenberg, B.; Kamilova, F. Plant-Growth-Promoting Rhizobacteria. Annu. Rev. Microbiol. 2009, 63, 541–556. [Google Scholar] [CrossRef]
- Aiello, D.; Restuccia, C.; Stefani, E.; Vitale, A.; Cirvilleri, G. Postharvest Biocontrol Ability of Pseudomonas Synxantha against Monilinia fructicola and Monilinia fructigena on Stone Fruit. Postharvest Biol. Technol. 2019, 149, 83–89. [Google Scholar] [CrossRef]
- Verhagen, B.W.; Trotel-Aziz, P.; Couderchet, M.; Höfte, M.; Aziz, A. Pseudomonas Spp.-Induced Systemic Resistance to Botrytis cinerea Is Associated with Induction and Priming of Defence Responses in Grapevine. J. Exp. Bot. 2010, 61, 249–260. [Google Scholar] [CrossRef] [PubMed]
- Bonaterra, A.; Mari, M.; Casalini, L.; Montesinos, E. Biological Control of Monilinia laxa and Rhizopus stolonifer in Postharvest of Stone Fruit by Pantoea Agglomerans EPS125 and Putative Mechanisms of Antagonism. Int. J. Food Microbiol. 2003, 84, 93–104. [Google Scholar] [CrossRef] [PubMed]
- Zhang, H.; Zheng, X.; Yu, T. Biological Control of Postharvest Diseases of Peach with Cryptococcus laurentii. Food Control 2007, 18, 287–291. [Google Scholar] [CrossRef]
- Wang, Y.; Tian, S. Interaction between Cryptococcus laurentii, Monilinia fructicola, and Sweet Cherry Fruit at Different Temperatures. Agric. Sci. China 2008, 7, 48–57. [Google Scholar] [CrossRef]
- Bautista-Baños, S.; Bosquez-Molina, E.; Barrera-Necha, L.L. Rhizopus stolonifer (Soft Rot). In Postharvest decay; Elsevier: Amsterdam, The Netherlands, 2014; pp. 1–44. [Google Scholar]
- Zhang, X.; Wu, F.; Gu, N.; Yan, X.; Wang, K.; Dhanasekaran, S.; Gu, X.; Zhao, L.; Zhang, H. Postharvest Biological Control of Rhizopus Rot and the Mechanisms Involved in Induced Disease Resistance of Peaches by Pichia Membranefaciens. Postharvest Biol. Technol. 2020, 163, 111146. [Google Scholar] [CrossRef]
- Cao, S.; Yang, Z.; Hu, Z.; Zheng, Y. The Effects of the Combination of Pichia Membranefaciens and BTH on Controlling of Blue Mould Decay Caused by Penicillium expansum in Peach Fruit. Food Chem. 2011, 124, 991–996. [Google Scholar] [CrossRef]
- Li, Y.; Ji, N.; Zuo, X.; Hou, Y.; Zhang, J.; Zou, Y.; Jin, P.; Zheng, Y. PpMYB308 Is Involved in Pichia guilliermondii-Induced Disease Resistance against Rhizopus Rot by Activating the Phenylpropanoid Pathway in Peach Fruit. Postharvest Biol. Technol. 2023, 195, 112115. [Google Scholar] [CrossRef]
- Zhao, Y.; Li, Y.; Zhang, B. Induced Resistance in Peach Fruit as Treated by Pichia guilliermondii and Their Possible Mechanism. Int. J. Food Prop. 2020, 23, 34–51. [Google Scholar] [CrossRef]
- Zhang, J.; Xie, J.; Zhou, Y.; Deng, L.; Yao, S.; Zeng, K. Inhibitory Effect of Pichia Membranaefaciens and Kloeckera Apiculata against Monilinia fructicola and Their Biocontrol Ability of Brown Rot in Postharvest Plum. Biol. Control 2017, 114, 51–58. [Google Scholar] [CrossRef]
- Wu, S.; Zhen, C.; Wang, K.; Gao, H. Effects of Bacillus subtilis CF-3 VOCs Combined with Heat Treatment on the Control of Monilinia fructicola in Peaches and Colletotrichum gloeosporioides in Litchi Fruit. J. Food Sci. 2019, 84, 3418–3428. [Google Scholar] [CrossRef]
- Bartlett, D.W.; Clough, J.M.; Godwin, J.R.; Hall, A.A.; Hamer, M.; Parr-Dobrzanski, B. The Strobilurin Fungicides. Pest Manag. Sci. 2002, 58, 649–662. [Google Scholar] [CrossRef]
- Wilingham, S.L.; Pegg, K.G.; Langdon, P.W.B.; Cooke, A.W.; Peasley, D.; Mclennan, R. Combinations of Strobilurin Fungicides and Acibenzolar (Bion) to Reduce Scab on Passionfruit Caused by Cladosporium Oxysporum. Australas. Plant Pathol. 2002, 31, 333–336. [Google Scholar] [CrossRef]
- Rahman, H.; Shovan, L.R.; Hjeljord, L.G.; Aam, B.B.; Eijsink, V.G.H.; Sørlie, M.; Tronsmo, A. Inhibition of Fungal Plant Pathogens by Synergistic Action of Chito-Oligosaccharides and Commercially Available Fungicides. PLoS ONE 2014, 9, e93192. [Google Scholar] [CrossRef]
- Smilanick, J.L.; Mansour, M.F.; Margosan, D.A.; Gabler, F.M.; Goodwine, W.R. Influence of pH and NaHCO3 on Effectiveness of Imazalil to Inhibit Germination of Penicillium Digitatum and to Control Postharvest Green Mold on Citrus Fruit. Plant Dis. 2005, 89, 640–648. [Google Scholar] [CrossRef]
- Mombert, P.; Guijarro Díaz-Otero, B.; Alonso-Prados, J.L. Study of the Different Evaluation Areas in the Pesticide Risk Assessment Process. EFSA J. 2022, 20, e200412. [Google Scholar] [CrossRef]
- Lazarević-Pašti, T.; Milanković, V.; Tasić, T.; Petrović, S.; Leskovac, A. With or Without You?—A Critical Review on Pesticides in Food. Foods 2025, 14, 1128. [Google Scholar] [CrossRef] [PubMed]
- Cucu, M.A.; Choudhary, R.; Trkulja, V.; Garg, S.; Matić, S. Utilizing Environmentally Friendly Techniques for the Sustainable Control of Plant Pathogens: A Review. Agronomy 2025, 15, 1551. [Google Scholar] [CrossRef]
- Strano, M.C.; Altieri, G.; Admane, N.; Genovese, F.; Renzo, G.C.D.; Strano, M.C.; Altieri, G.; Admane, N.; Genovese, F.; Renzo, G.C.D. Advance in Citrus Postharvest Management: Diseases, Cold Storage and Quality Evaluation. In Citrus Pathology; IntechOpen: London, UK, 2017; ISBN 978-953-51-3072-7. [Google Scholar]
- Mahajan, P.V.; Caleb, O.J.; Singh, Z.; Watkins, C.B.; Geyer, M. Postharvest Treatments of Fresh Produce. Philos. Trans. A Math. Phys. Eng. Sci. 2014, 372, 20130309. [Google Scholar] [CrossRef] [PubMed]
- Ons, L.; Bylemans, D.; Thevissen, K.; Cammue, B.P.A. Combining Biocontrol Agents with Chemical Fungicides for Integrated Plant Fungal Disease Control. Microorganisms 2020, 8, 1930. [Google Scholar] [CrossRef]

| Pathogen | Disease | Entry Point | Optimal Conditions | Symptoms | Ref. |
|---|---|---|---|---|---|
| Monilinia spp. | Brown rot | Wounds, lenticels, stem-end | 20–25 °C, high humidity | Brown lesions, concentric conidial rings | [9] |
| Penicillium expansum | Blue rot | Wounds, calyx, bruises | 5–25 °C, high humidity | Soft watery rot, blue-green sporulation | [21] |
| Rhizopus stolonifer | Soft rot | Mechanical injuries, bruises | 23–28 °C, Relative Humidity (RH) > 95% | Rapid softening, watery leakage, cottony growth | [31] |
| Botrytis cinerea | Gray rot | Wounds, intact cuticle (under stress) | 15–25 °C, RH > 90% | Gray sporulation, brown wet spots, tissue collapse | [43] |
| Geotrichum candidum | Sour rot (Acid rot) | Skin injuries, contamination | 25–28 °C, acidic pH | Soft, watery rot with a sour smell, white growth | [52] |
Disclaimer/Publisher’s Note: The statements, opinions and data contained in all publications are solely those of the individual author(s) and contributor(s) and not of MDPI and/or the editor(s). MDPI and/or the editor(s) disclaim responsibility for any injury to people or property resulting from any ideas, methods, instructions or products referred to in the content. |
© 2025 by the authors. Licensee MDPI, Basel, Switzerland. This article is an open access article distributed under the terms and conditions of the Creative Commons Attribution (CC BY) license (https://creativecommons.org/licenses/by/4.0/).
Share and Cite
El Maazouzi, S.; Asfers, A.; Cano, A.; Hernández-Ruiz, J.; Hamdache, A.; Ait Houssa, A.; Ezziyyani, M.; Arnao, M.B. Peach Postharvest Fungal Diseases: Sustainable Management and an Integrative Review of Emerging Strategies. Crops 2025, 5, 84. https://doi.org/10.3390/crops5060084
El Maazouzi S, Asfers A, Cano A, Hernández-Ruiz J, Hamdache A, Ait Houssa A, Ezziyyani M, Arnao MB. Peach Postharvest Fungal Diseases: Sustainable Management and an Integrative Review of Emerging Strategies. Crops. 2025; 5(6):84. https://doi.org/10.3390/crops5060084
Chicago/Turabian StyleEl Maazouzi, Sahar, Adil Asfers, Antonio Cano, Josefa Hernández-Ruiz, Ahlem Hamdache, Abdelhadi Ait Houssa, Mohammed Ezziyyani, and Marino B. Arnao. 2025. "Peach Postharvest Fungal Diseases: Sustainable Management and an Integrative Review of Emerging Strategies" Crops 5, no. 6: 84. https://doi.org/10.3390/crops5060084
APA StyleEl Maazouzi, S., Asfers, A., Cano, A., Hernández-Ruiz, J., Hamdache, A., Ait Houssa, A., Ezziyyani, M., & Arnao, M. B. (2025). Peach Postharvest Fungal Diseases: Sustainable Management and an Integrative Review of Emerging Strategies. Crops, 5(6), 84. https://doi.org/10.3390/crops5060084









